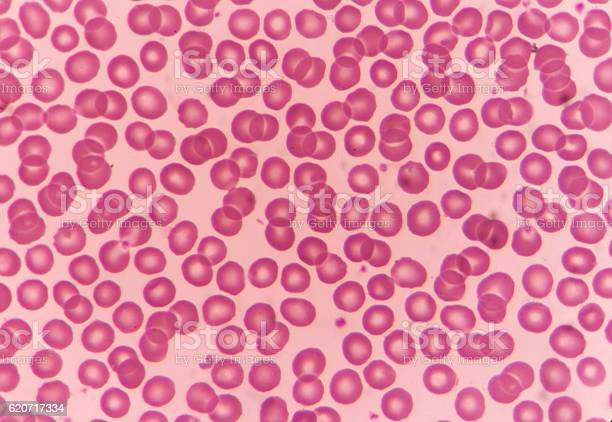
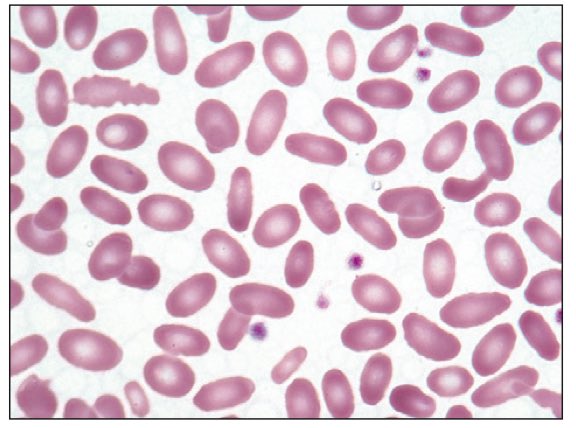
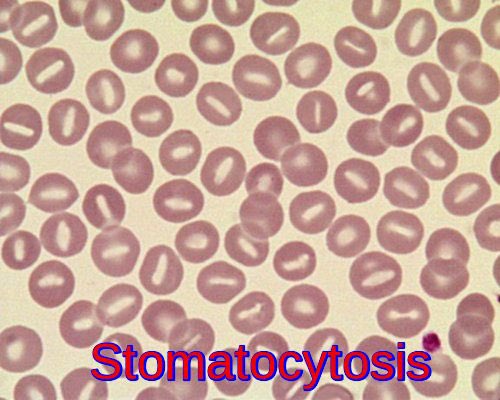
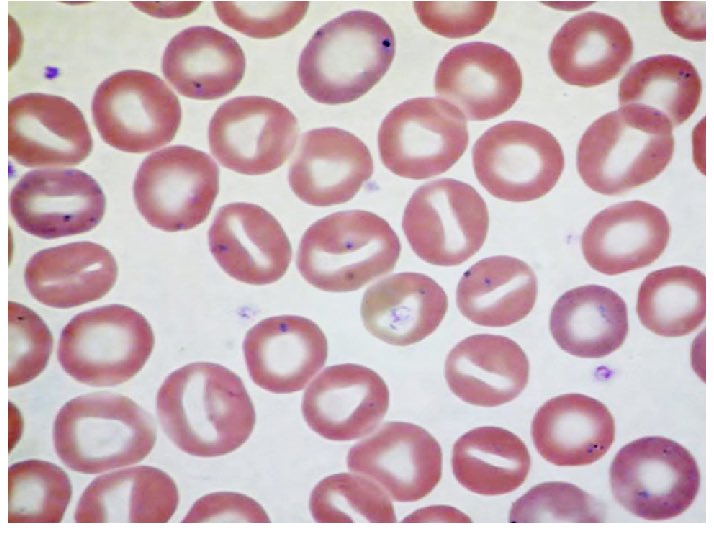
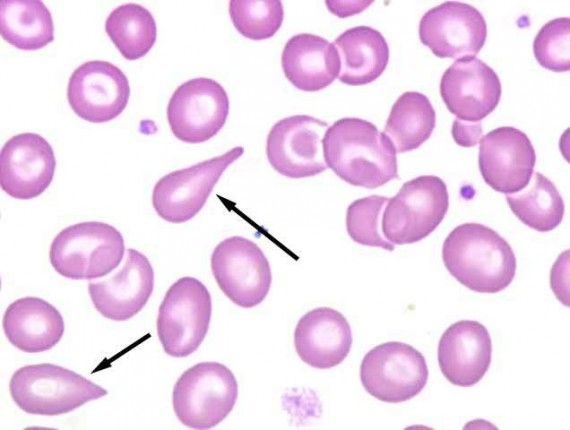
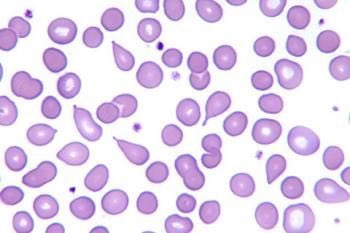
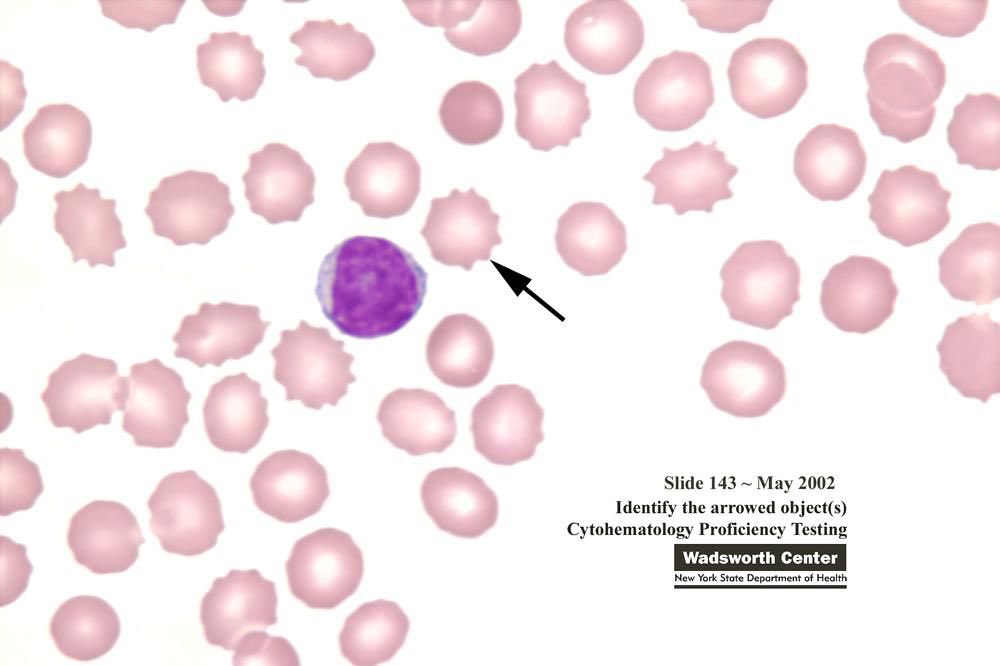
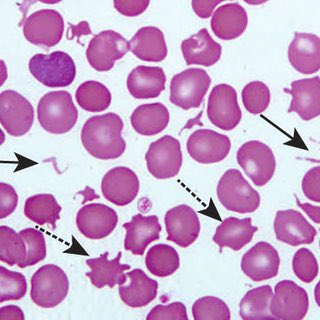
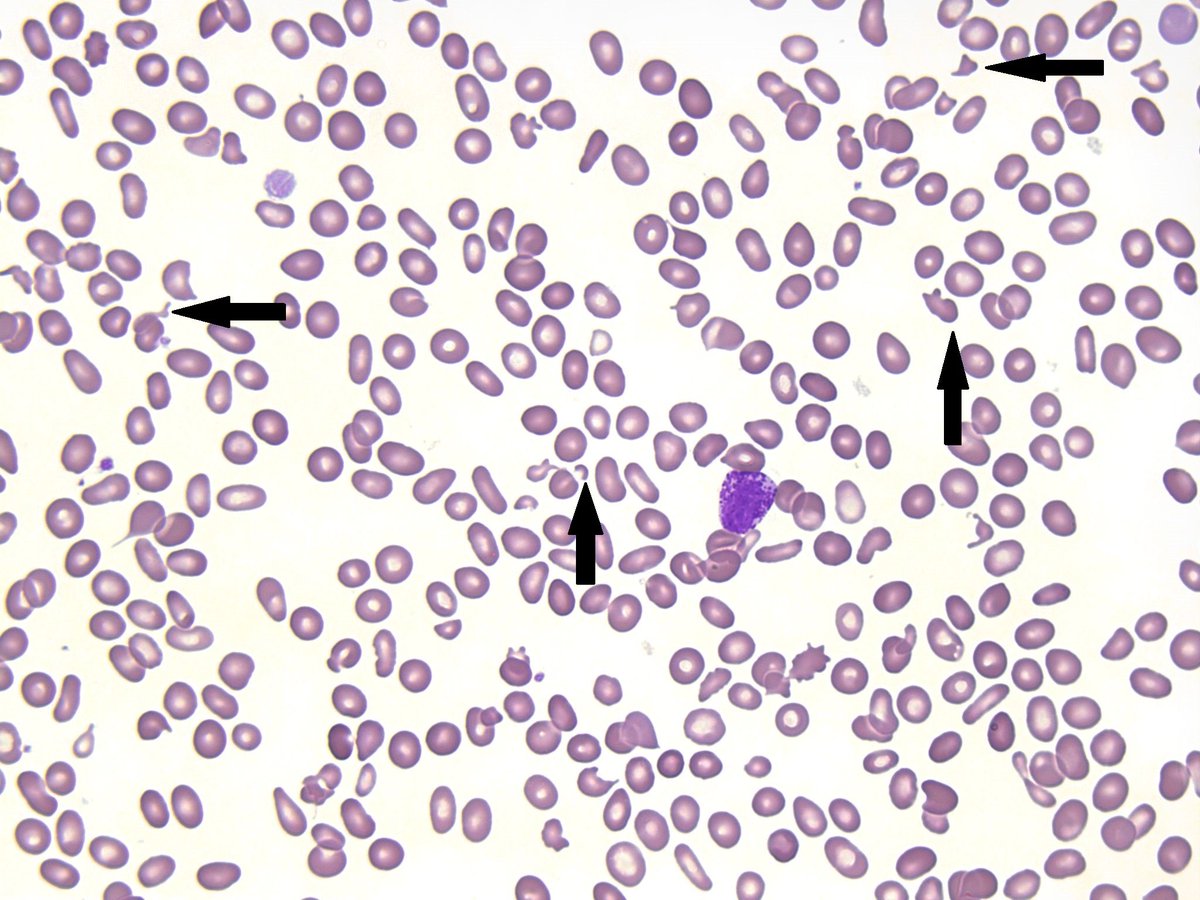
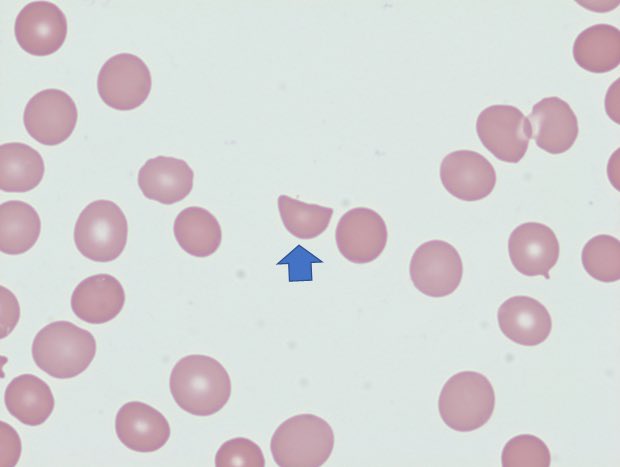
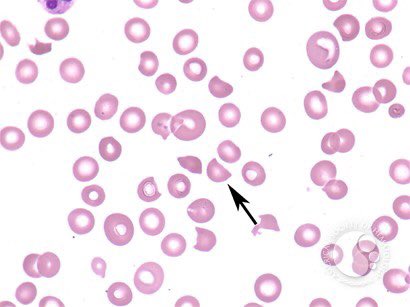
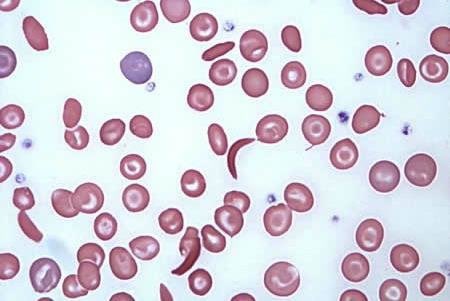
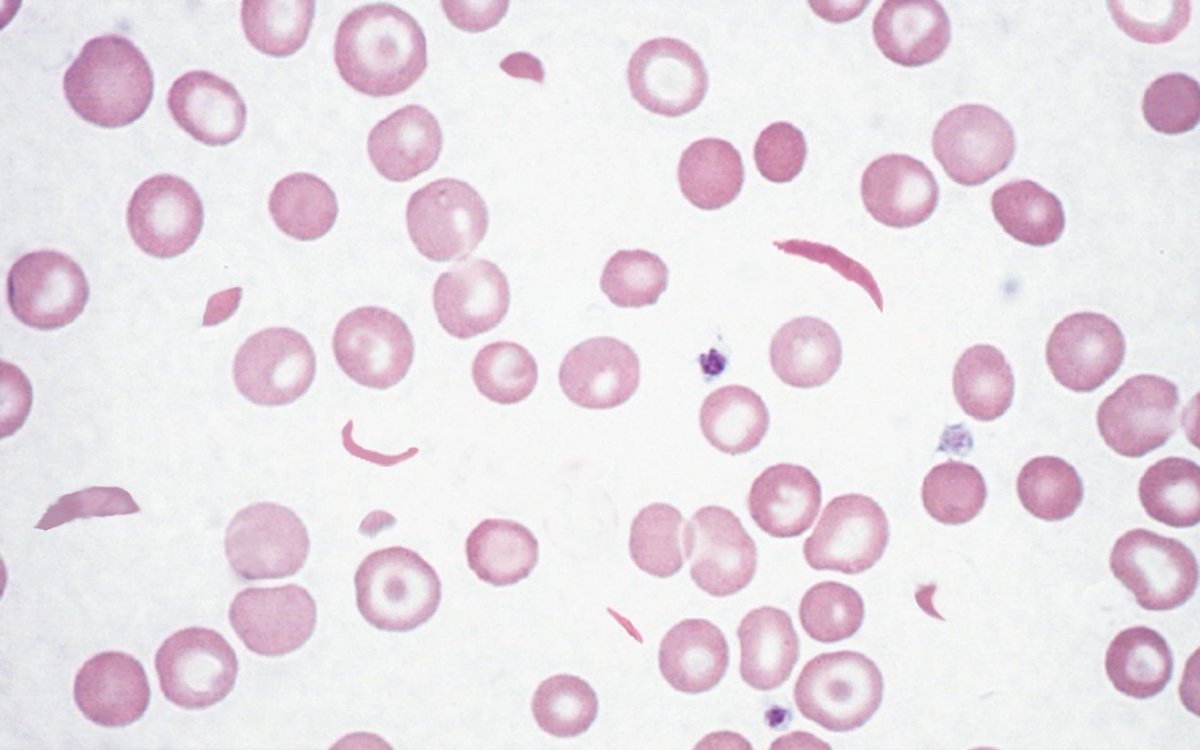

في ثريد سابق ذكرت انواع الشوائب والتفاصيل الي ممكن نلاقيها داخل خلايا الدم الحمراء نفسها كمان شيكوا عليه 🔽✨
جاري تحميل الاقتراحات...